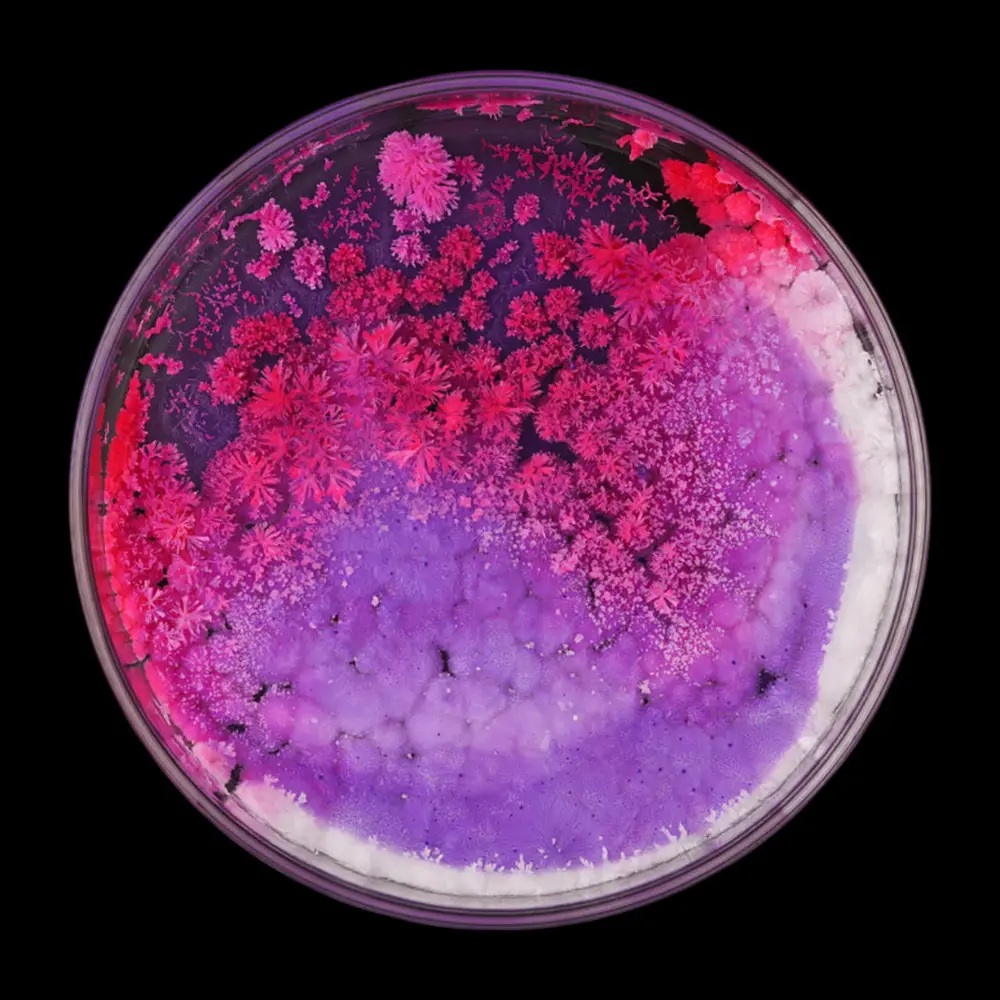
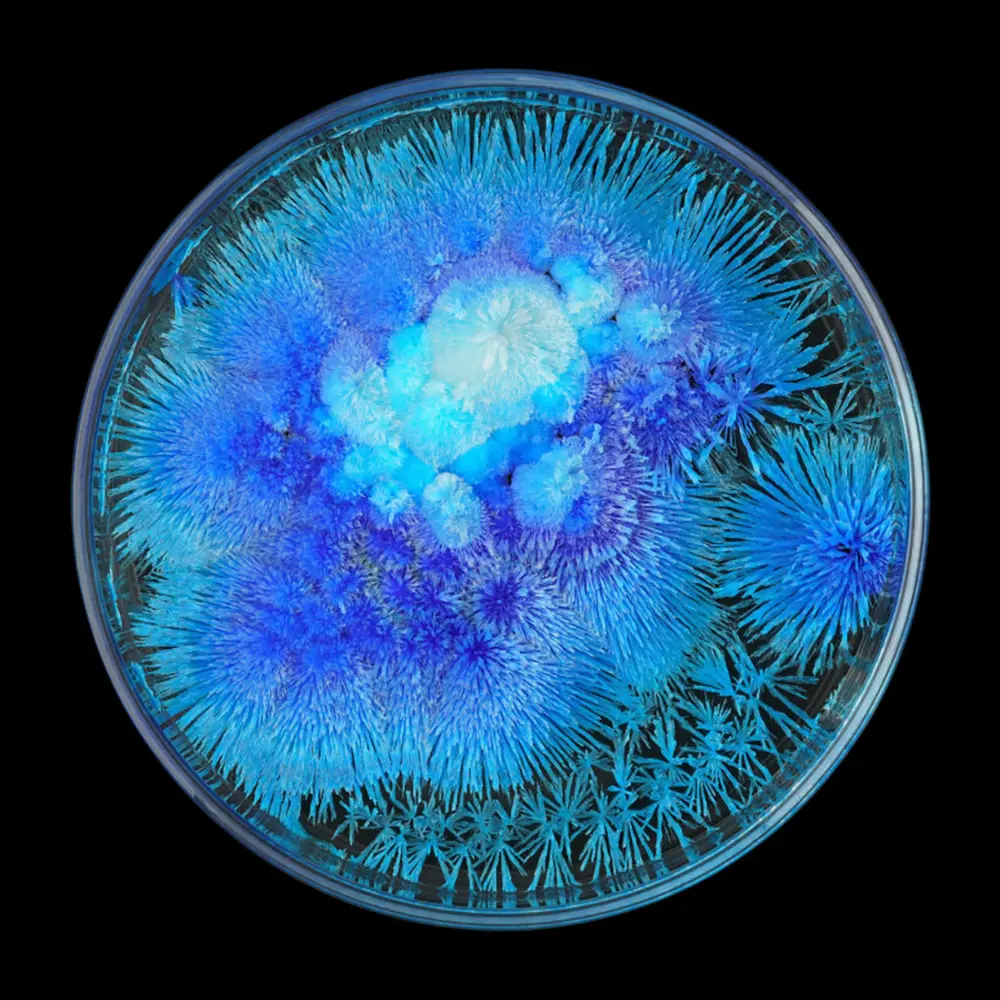
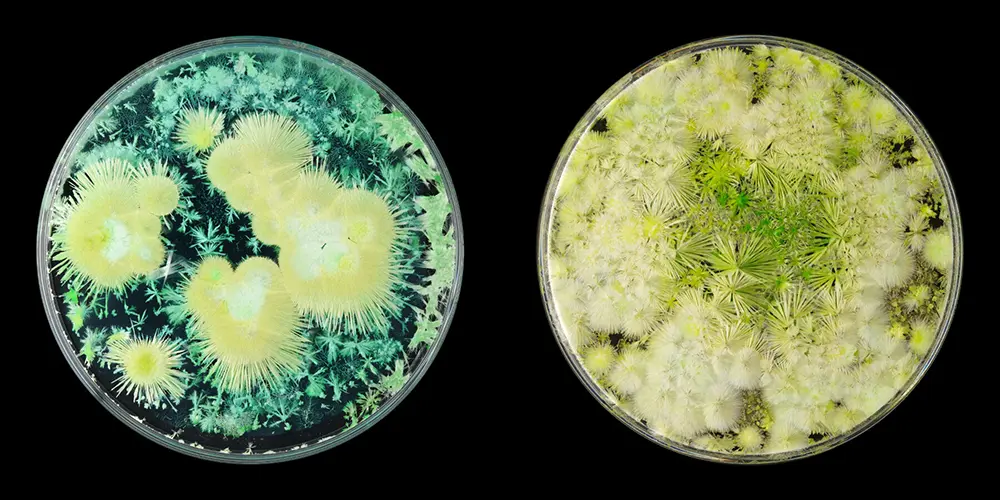

project info:
name: Crystal Garden: Seasons
collective: Beauty of Science
Have you ever looked at a chemical reaction and thought, “Wait, that belongs in a museum”? That’s exactly the vibe of Crystal Garden: Seasons. Created by the collective Beauty of Science, this project is a stunning collaboration between human intention and the “wild” side of chemistry.
The artist sets the stage—adjusting the temperature and saturation—and then simply steps back. Inside simple glass Petri dishes, colorful crystals begin to bloom on their own. It’s not just a science experiment; it’s a living landscape that grows, branches, and thickens over days until it looks like a tiny, mineral forest.
A Garden That Grows Itself
The name Crystal Garden: Seasons is actually a perfect metaphor. Just like a real garden, it’s a space where humans and nature work together. Each dish captures the “mood” of a season: icy blues for winter, deep reds for autumn, and lush greens for spring.
What I love most about this series by Beauty of Science is the patience involved. These colorful crystals follow their own organic cadence, multiplying into “mineral thickets” that feel deeply poetic. By using glass Petri dishes as a canvas, the team has managed to capture the uncontrollable force of nature in a way that feels both modern and ancient. It’s a beautiful reminder that sometimes, the best art happens when we just let nature take the lead!